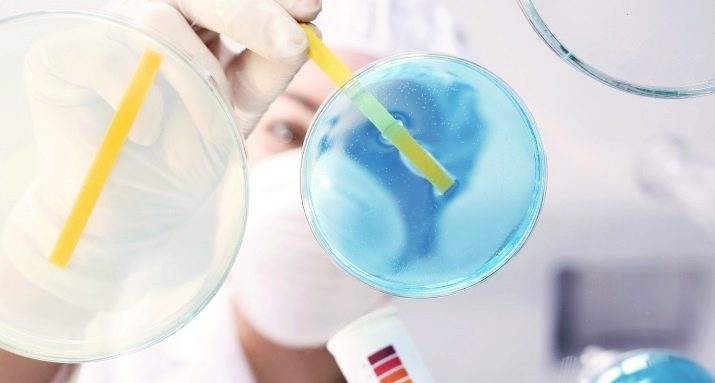

Aquarium is a real decoration of any room, as well as a fascinating means of observing the world of fish and their interaction. Many are ready to decide to become the owner of such a reservoir. However, not everyone knows that to maintain it in good condition, it is necessary to carefully monitor and care for its inhabitants, as well as conduct regular procedures that maintain a favorable microclimate inside the tank. What are the basic rules for caring for a fish tank and what are the nuances of various procedures will be described in detail in this article.



Basic Rules
To make the aquarium a real work of art, and all its inhabitants experience maximum comfort, Any novice tank owner should remember the following rules for its use and care.
- When you first equip a tank and fill it with water, wait about a week for the chlorine to evaporate. You can additionally use adapters, but only after consulting with an experienced specialist. After a week, you can launch fish into the tank, but it is better to start with the most picky species. You can also start to populate the aquarium with flora and only after 2 weeks start the fish.
- The volume of the aquarium should not be too small. Most fish love space, so the best option would be a tank, the volume of which is from 80 to 100 liters. A smaller tank can be purchased as a backup option for quarantine, in addition, an additional capacity is necessary for the reproduction of some fish.
- Flora is an essential component of a good aquarium, therefore at least a few living plants should be placed in the tank. So that they successfully grow at home, care should be taken of them, in particular, fertilize. A good option is to apply fertilizer under a layer of soil. Red clay may become such a component. Only 1 cm of such a layer will contribute to a more intensive growth of plants, especially in the initial stages.
- If you want to use natural river stone as soil, then it must be decontaminated so that there is no risk of infection of fish with infections. To do this correctly, first wash the stones well in cold water, then boil them for 15-20 minutes and rinse again.
- You should take care of the maximum comfort of the inhabitants of your tank.. Keeping fish requires special attention even at the stage of planning their purchase. It is important to choose them so that the species get along with each other and do not pose a threat to each other. For example, large predators are meaningless to keep in one tank with small peaceful aquarium fish. To avoid mistakes, carefully study the recommendations for the aquarium neighborhood for each individual.
- Choosing a decor for the aquarium, for example, sticks or stones, make sure that these objects do not have too sharp corners. Otherwise, the fish can damage their scales or even get injured.
- Cleaning the tank should be done at least once every 2 weeks. Before it starts, it is recommended that you turn off all equipment and drain approximately 10% of the total water volume. This will prevent you from splashing water when cleaning.
- Do not place the aquarium in a draft. This can affect the temperature of the water, especially if the tank does not have a heater with auto mode.
- Do not forget to inspect the fish for changes in appearance and behavior. The most convenient time for this procedure is feeding, since most individuals swim in search of food.



Removal of unwanted plants
Even in the tank in which all purity indicators are maintained, algae can periodically form on the walls. They can be removed using the following methods and tools.
- Depending on the type of algae, they can be removed as brushes.by winding fibers on a rough surface, and tweezers if, for example, these are species that have formed and are firmly entrenched on stones.
- Another way to get rid of unwanted plants will be to change favorable conditions for their development. To do this, you need to shade the aquarium, turn off the oxygen filtration and supply system, and partially replace the water until the algae disappears. For higher flora for some time in such conditions it will not be destructive. This procedure takes several weeks. Do not turn on the light in the tank without making sure that all the unfavorable plants have disappeared, otherwise all the work will be in vain. Also during this period, make sure that the fish eat all the food.
- You can reduce the number of algae by increasing the number of plants of higher classes while reducing the number of fauna representatives. In this case, you need to strengthen the lighting and bring its duration to 12 hours. Every day, you should also clean the soil and change 10% of the volume of fluid to fresh.
- One of the life hacks for cleaning the tank from algae is the introduction of copper sulfate. In this case, you need to transplant all the inhabitants of the aquarium into another container. 1 g of sulfate or 1 to 10 ml of solution should be taken per 1 liter of water. The concentration should first be small, gradually increasing in the absence of the proper result. When the algae disappears, you must first replace the water in the tank at least three times and only then start the fish back.
- The last option is to use special drugs to get rid of algae. They must be made in strict accordance with the instructions.


We monitor the purity of water
The life and comfort of its inhabitants depend on factors such as the purity and chemical composition of the water in the home aquarium. It is important to remember that the purity of water and its compliance with the standards for acidity and hardness should be determined using a test reagent, collecting water in a separate container and immersing the indicator in it. Within 5 minutes after that you will get the result.
Regular checks of these indicators are needed.
Maintaining a clean aquarium also includes a number of mandatory procedures.
- Filters in cleaning systems are constantly contaminated and as this happens, they need to be changed. In this case, the filter should only be cleaned in aquarium water. If it is cleaned under a flowing stream, the water balance of the tank may be disturbed.
- To maintain cleanliness in fish tanks water must be replaced periodically. If after the first start-up this procedure can be carried out after several months, then subsequently the water is replaced approximately once a week (according to the needs of the inhabitants of the reservoir). Not all volume needs to be replaced at a time. Usually it is a quarter or a third of the volume of the aquarium.
- Watch for hardness and acidity. The best option for the first of them is from 3 to 15 units, depending on the needs of the inhabitants, and the acidity should not go beyond the range of 6 to 9 pH.
- Watch for water clarity. Turbidity during cleaning procedures may indicate problems with the filter.


We use special equipment
To take care of the fish and maintain cleanliness in the aquarium was easier, you should acquire special equipment to help cope with the aquarium routine or serve as an additional tool for monitoring changes in the state of water in the tank. The following equipment can be attributed to devices for beginners and more experienced aquarists.
- An internal filter is required to collect suspended soil particles, which may form unwanted sludge. The size of the filter is selected depending on the volume of your container.

- For aeration of fluid in the aquarium, you should purchase a special device - an air vibrator pump. It enriches water with oxygen, which is necessary for some inhabitants of a home reservoir.
To prevent this process from hitting, clean the sprayer from plaque or replace the sprayer if cleaning does not help. The air valves of the device also need to be cleaned and replaced regularly every six months.

- Better to monitor the condition of fish and water will help light sources that can be mounted in the aquarium, even independently. For this, fluorescent lamps, such as LD or LB, are usually used. The latter type of lamp is especially preferred for reservoirs with living flora, since it contains rays of the red spectrum, contributing to the growth of underwater greenery. It is better to give preference to energy-saving devices, whose power is 25 watts.
However, even they should be changed every 6-8 months, since with constant use, the light becomes dimmer over time.

- Since the water in the aquarium may cool depending on the room temperature, To maintain a suitable microclimate for some inhabitants, it is necessary to use a special heater.
It is worth paying attention to such models that can work in automatic mode, because thanks to them, a constant temperature can be maintained in the tank.

- However, in order to understand whether it is necessary to heat water or, on the contrary, whether its temperature is too high, it is necessary to use a thermometer. There are special aquarium models that attach directly to the wall of the aquarium and always show how many degrees the temperature of the water is.

- To feed the fish more conveniently, you need to have a special feeder. It is a round or square plastic container with a hole in the middle, in which there is dry or live food.
In particular, such an accessory makes feeding dry food easier, preventing it from spreading around the aquarium. For live nutrition, tweezers are also useful.


- Sometimes you need to consider any details or changes to the home underwater world in more detail. To do this, use a magnifying glass or magnifier.

- Be sure to get a pair of net for fish transplant. One must be designed specifically for the quarantine tank.

- Use a special hose to drain the water.

- To clean the tank of algae, you should purchase special brushes. Remember that their blades must be plastic, otherwise there is a big risk of scratching the glass.
For hard-to-reach areas, even a regular toothbrush can do.

- To clean the soil, special funnels are needed, with which you can get rid of unwanted pollution.

For tips on caring for the round aquarium and keeping the fish in it, see the next video.










